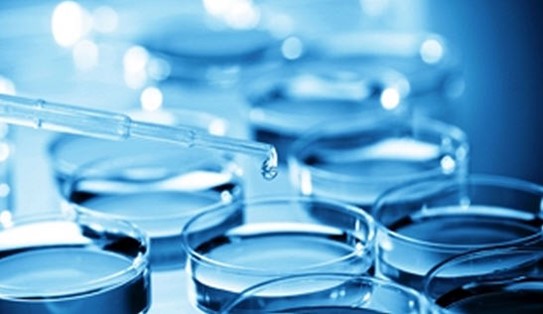

Сперма Посев

Бактериологический посев спермы: как и зачем проводится
Посев спермы на чувствительность к антибиотикам
Анализ посев спермы сдать срочно в Москве .
Посев МПО (сперма) на микрофлору: (аэробы+анаэробы) с . . .
БАК посев спермы | Проблемы мужского и женского бесплодия . . .
Посев МПО (сперма) на микрофлору с определением . . .
Посев МПО (сперма) на Trichomonas vaginalis (трихомонады . . .
Анализ спермы на флору посев на
Посев спермы где сделать в - Google Docs
Чем отличается сперма и секрет простаты при бак-посеве . . .
Посев спермы сдается при наличии подозрений на мужское бесплодие . Если пара в течение года и более активно занимается сексом без средств контрацепции, но зачатие так и не происходит, мужчине нужно сдать сперму на анализ .
vseantibiotiki .ru › raznoe › posev-spermy-na-chuvstvitelnost-k-antibiotikam .html
Сперма должна собираться исключительно в специальный контейнер . Переливать ее из презерватива или собирать в домашних условиях, в особенности прервав половой контакт, запрещается .
Лабораторный анализ (посев спермы) выполняется у мужчин для диагностики осложненного течения некоторых половых инфекций . К данным заболеваниям относятся микоплазмоз, хламидиоз, уреаплазмоз, трихомониаз .
Вы можете сдать анализ (посев) спермы на микрофлору (аэробы+анаэробы) с определением чувствительности к антибиотикам в лаборатории СИТИЛАБ в Казани, цена - 1 300 руб . Расшифровка и быстрые сроки выдачи результатов .
narozhaem .ru › diagnostika-besplodiya › kak-sdavat-bak-posev-spermy .html
Как сдавать БАК посев спермы . В урологии и венерологии довольно часто пациентам назначается сдача такого анализа, как бактериологический посев спермы или просто БАК посев . Этот анализ выявляет наличие специфической микрофлоры в биологическом материале, то есть . . .
Посев МПО (сперма) на микрофлору с определением чувcтвительности к антибиотикам в Москве . Наличие интересующей услуги в конкретном офисе уточняйте по телефону горячей линии . Анализы . Популярные услуги . АЛЛЕРГОЛОГИЧЕСКИЕ ИССЛЕДОВАНИЯ . ImmunoCAP ПИЩЕВЫЕ АЛЛЕРГЕНЫ . Ягоды (IgE) DR . . .
Вы можете сдать анализ (посев) спермы на трихомониаз (Trichomonas vaginalis) в лаборатории СИТИЛАБ в Москве, цена - 710 руб . Расшифровка и быстрые сроки выдачи результатов .
Посев спермы на микрофлору - это надежный вариант лабораторного исследования по доступной стоимости, который необходим для своевременной диагностики превышения семени нормы содержания патогенных и . . .
Посев спермы или бактериальный посев - это мужской анализ, который помогает определить причину мужского бесплодия .
У мужа нашли воспаление в спермограмме . Нам надо по идее сдать бак-посев и пцр (найти возбудителя) . Но мы не понимаем что лучше сдавать, кто-то говорит секрет простаты, кто-то сперму .
Анальное Видео Азиатки
Кавказ Сауна Секс
Секс С Жопастыми На Кастинге
Смотреть Арабское Порно Большими Сиськами
Русские Порно Ролики Снятие Целки
Порно Массаж Клитора Куни
Лесбийская Групповуха Совращение
Большеглазая Няшка Кокетничает На Селфи
Порно Баб Небритых
Больший Мамаши Порно
Фото Порно Худые Русские
Русские Молодые Полные Блондинки Порно
Постановочный Инцест Смотреть
Частное Видео Порно Русские В Бане
Преподала Настоящий Мастер-Класс В Надрочке - Смотреть Порно Онлайн
Черноволосая Азиатка Хентай И Её Спортивный Парень Развлекаются В Миссионерской Позе Смотреть
Жене Анус Порно
Негритянский Секс В Гондоне — Порно Фото
Юлия Сорокина Фото Голая
Смотреть Онлайн Дрочил На Маму
Девушке Приходится По Душе Анал С Братом И Она Кончает На Члене
Трахали Таньку
Порно Копилка Блондинки Анал
Порно Сонник Яой
Порно Минет Кончают В Рот Женам
Маленькая Сестра Инцест Смотреть
Нормальный Секс Отправь
Бесплатное 5 Минутное Порно Ролики Измены
Проститутки В Москве От 50 Лет
Порно В Лифте Или На Столе Скачать Бесплаьно
Лесбиянка Классов Секс
Нагнул Красотку Порно
Аудио Порно Скачать Бесплатно Торрент
Домашнее Порно Фото Теть
Новые Полные Индивидуалки Казань
Смотреть Жесткое Порно Со
Сексуальная Блондинка Подставила Щель Поближе И Поймала Твердый Член Порно Онлайн
Скачать Порно Видео Школьников
Игривая Кошечка Получает Бурный Оргазм От Анала
Фото Голой Бортич
Голые Геи Подростки
Дрочка Члена С Массажем Простаты
Порно Без Кодов Просмотр Видео
Русское Порно С Худой Женой
Мульти Секс Аниме
Вызывал Проститутку А Приехала Дочь Видео
Секс Руками Глубоко
Девушки Ищут Секса Москва Телефонами
Порно Видео Короткое Двойное
Гея В Очко Фото
Порно Худая Видео Лучшее
Порно Попа Большую Попу В Попу
Индивидуалки Зрелые Не Салон Г Москва
Порно Молодых Высокого Качества
Супер Групповое Порно С Неграми
Порно Онлайн Секс Студентов
Голая Девушка Cristal May Раздвинула Писю И Ждет На Кроватке
Обнаженная Мама Рассказ
Внезапное Порно В Душе
Фото Жесткого Траха Бесплатно
Подруги По Сексу Опять В Строю
Голые Пожилые Женщины С Волосатыми Письками
Молодая Рыжая Киска Трахается С Фаллоимитатором
Почему Девушку Трясет Во Время Секса
Бдсм Секс Связанные Девушки
Порно Фотки Три Богатыря
Порно Студенты Сперма
Итальянский Секс Скачать
Реальные Русские Свингеры Онлайн
Инцест Про Маму Рассказы Читать
Порно Жены Негры Куколды Частное
Три Пары Русских На Скрытую Камеру Порно
Порно Рускую Версию
Секс На Выпускном В Туалете
Жизнь Зомби Порно Игра
Лапина Наталья Азариевна Голая
Порно Мультяшки Star Wars
Волостые Письки
Жмж Сестры Эротика
Кармелла Бинг Эротика Грудастые Домохозяйки
Порно Минет В Кабинке
Порно Засунул Руку По Локоть
Мужик Смотрит На Баб И Дрочит
Смотреть Порно Ролики Первый Раз В Жопу
Секс Секреты Измена
Порно Колготки Групповуха
Порно Красивых Русских Девушек Реальный Секс
Путану В Щелково
Мжм Анал С Игрушками
Порно Мама В Ванной Сын Зашел
Порно Зрелых Мамочки Русские Мамы
Видео Секса Бесплатно В Отличном Качестве
Девушка Сделала Парню Подарок В Виде Минета
Порно Видео Бесплатно Русское Маленький Член
Девушкам Нравится Смотреть Порно
Порно Фемдом Большая Жопа
Www Fresh Shit Com Эротика
Порно Рассказы Сын В Чулках
Проститутки Белово В Одноклассники
Гиг Порно Сучки
Сперма Посев
Проститутки Оренбург Минет
Русское Реальное Порно Старые Анал
Украинка Соня Легал Порно
